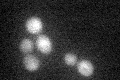
YHR034C
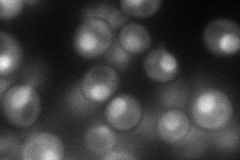
YHR034C
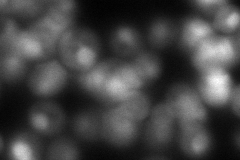
YHR034C
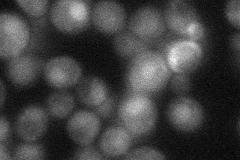
YHR034C

View description
Protein of unresolved function; may function in protein folding and/or rRNA processing, interacts with a chaperone (Hsp82p), two chromatin remodeling factors (Rvb1p, Rvb2p) and two rRNA processing factors (Rrp43p, Nop58p)
Localization:
Intensity:
Fold change:
Significance:
-
C’ GFP library in SD
nucleus,cytosol24.05 -
N' NOP1pr-GFP in SD
cytosol,nucleus67.5659 -
N' TEF2pr-mCherry in SD
cytosol,nucleusN/A -
N' NATIVEpr-GFP in SD
nucleus34.2284 -
N' TEF2pr-VC and Cyto-VN in SD

nucleus35.9383 -
C’ GFP library in SD+DTT

nucleus,cytosol23.260.96No -
C’ GFP library in SD+H2O2

nucleus,cytosol23.990.99No -
C’ GFP library in Starvation Media

nucleus,cytosol23.260.96No -
C’ GFP library on the background of Pup2-DaMP

N/A -
C’ GFP library on the background of CCT mutant

N/A0N/AYes
